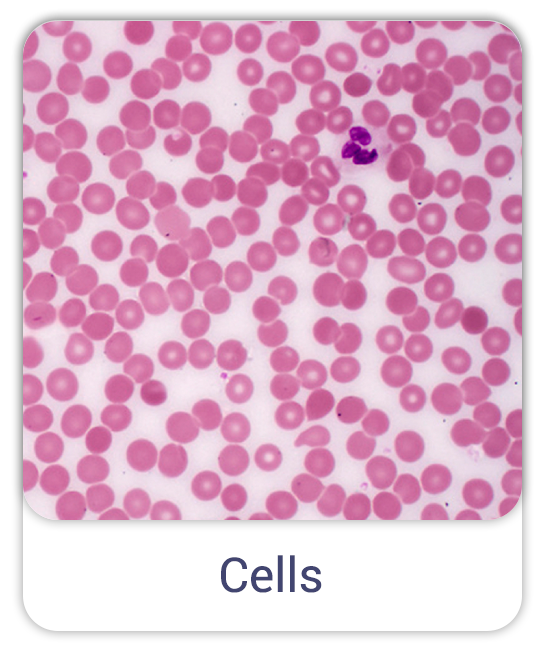

How does it work?
Choose template
Choose a template similar to the objects you need to count

Take a photo
Point your camera to the center of the objects group and take a photo

Review and save
Review the result and save
in built-in notebook

Used by many industries
Get in touch
If you have any questions, just fill in the contact form, and we will answer you shortly.